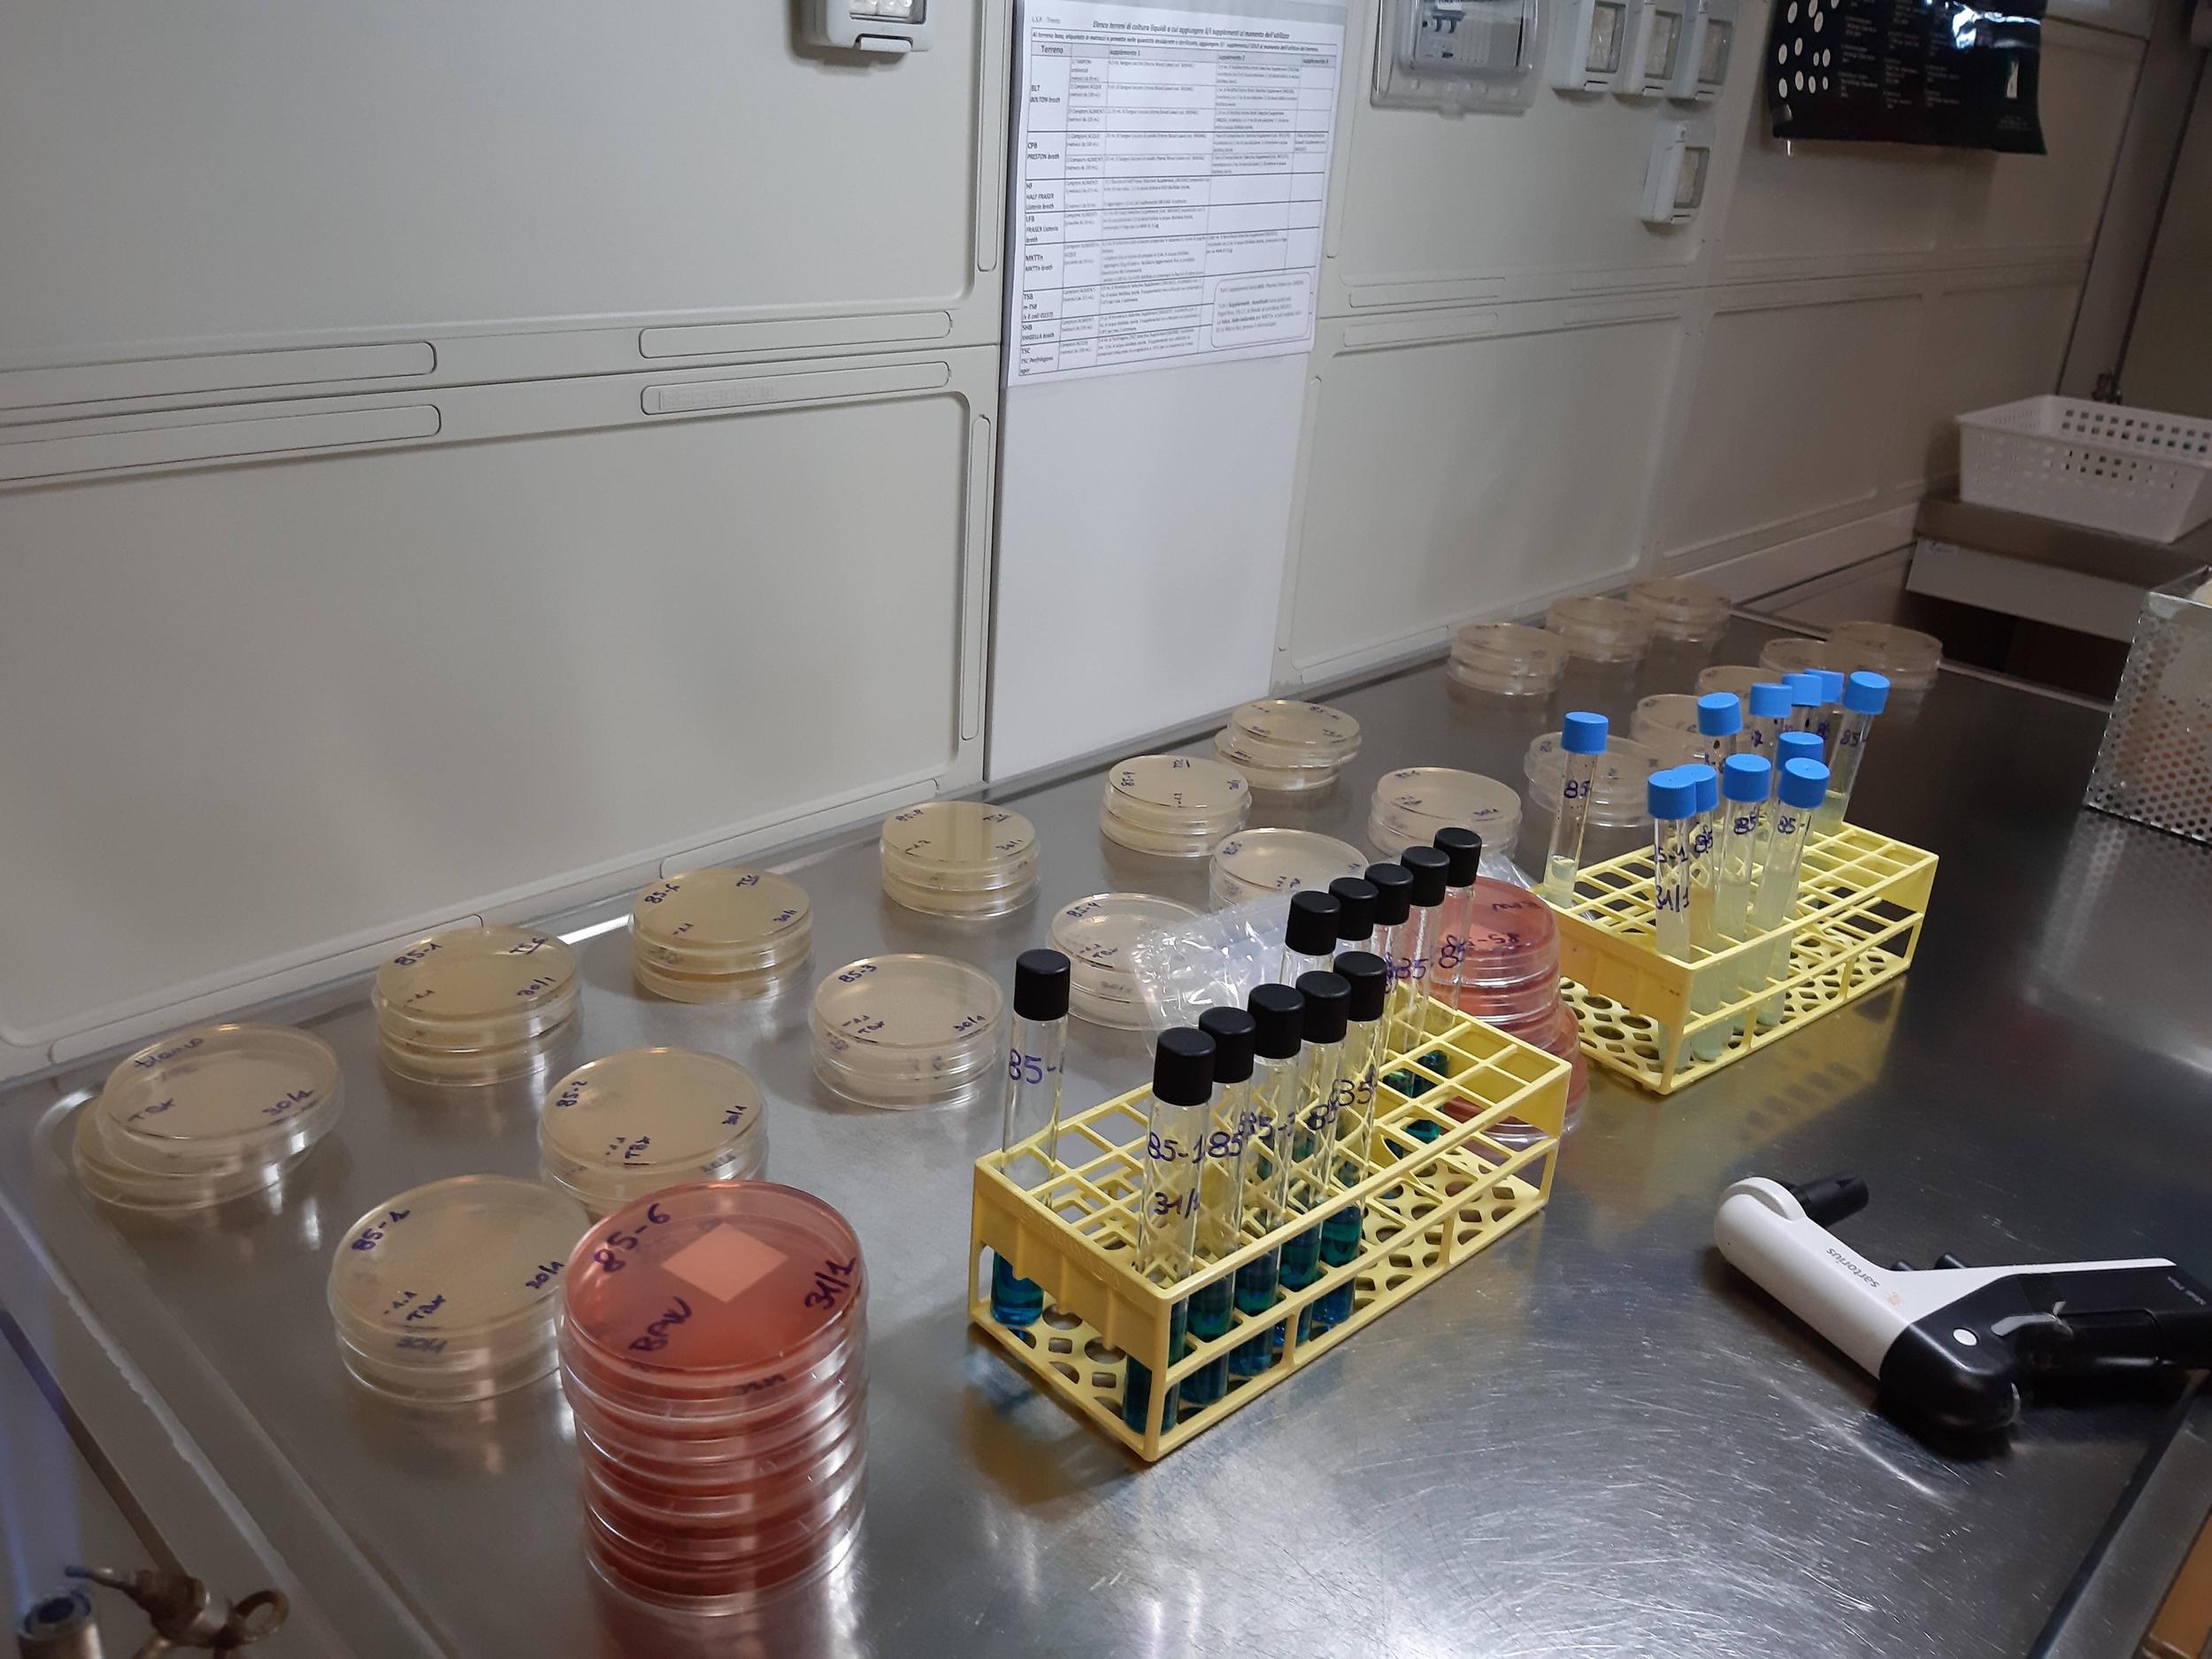
Immagine: laboratorio igiene pubblica

Non si è registrato alcun ricovero in ospedale e le persone coinvolte non hanno problemi clinici rilevanti ma solamente sintomi come nausea, vomito o diarrea. Non sono ancora note nel dettaglio le cause del malessere e il Dipartimento di prevenzione sta effettuando le verifiche e le indagini epidemiologiche e ambientali necessarie per risalire con precisione all’origine del problema che riguarda unicamente dipendenti Apss e non i pazienti ricoverati in ospedale.
Rovereto: sospetta intossicazione alimentare tra i dipendenti Apss
Sono stati riscontrati 27 casi di gastroenterite acuta non grave tra i dipendenti dell’Apss che hanno pranzato ieri nella mensa aziendale all’Ospedale di Rovereto.Data di pubblicazione:Venerdì, 08 Luglio 2022